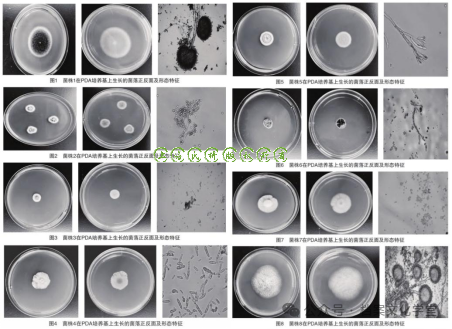
图片

摘要:低温冷冻是档案馆防范有害生物危害的常见处理措施。本文对经过低温冷冻处理的档案黑色疑似霉斑进行采样,结合形态学观察、ITS测序、18S测序结果对样品进行鉴定,结果发现仍存在可以培养成活的霉菌,且从生长特性以及代谢产物来看,均为会对档案载体产生危害的菌种,亟待采取有效防治措施。然后通过在高湿环境下纸张生霉的模拟实验,观察霉菌在纸质载体表面着生的状态、霉斑的形成过程,尽管采用75%酒精擦除,霉菌菌丝在纸张纤维内仍存在残留,最后结合一家档案馆连续三年的温湿度趋势分析,对档案馆检查和修复生霉档案提出建议。
关键词 纸质档案;霉斑;形成;去除

引言
微生物危害是纸质档案面临的最主要病害之一,对纸质档案影响较大的微生物主要是霉菌。霉菌在档案上着生会形成有色的霉斑污损档案、覆盖字迹,影响可读性。在生长的不同阶段,在不同的载体以及不同的营养条件下,霉菌生长所产生的代谢产物,呈现的颜色也不相同。霉菌在载体表面定殖,形成肉眼可见的菌落色斑。纸质档案中含有的纤维素、半纤维素等持续为微生物生长提供碳源、氮源、水分等营养,档案受到污染导致酸度增加、强度下降,并具有继续蔓延生长和孢子传播影响其他档案纸张的潜在危害。
本文首先以档案上的黑色疑似霉斑为研究对象,对其进行活性分析,然后模拟纸张生霉的过程,观察霉菌在纸张上的着生状态,霉斑的形成和酒精去除效果,最后结合档案馆库房温湿度趋势分析,对档案保护提出建议。
纸质档案黑色霉斑活性分析及其实验结果
对档案馆纸质档案边缘黑色疑似霉斑进行取样,将样品接种到PDA培养基中,倒置放入恒温箱28℃培养72小时,观察是否有霉菌生长。经采样、分离和纯化、菌落形态观察、ITS和18S测序,培养基中长出黑色、墨绿、粉色、白色等不同菌落形态的微生物。实验表明,纸张档案边缘的黑色霉斑具有活性。根据微生物的菌落形态学特征和分子鉴定得出档案黑色霉斑的微生物主要是曲霉属、青霉属、镰孢属、毛壳属、枝孢菌属。
(1)菌落形态学观察结果
菌落的形态是培养后所呈现的性状、大小、颜色、纹饰及组成等。不同种的真菌菌落的形态往往差异很大。将样本中分离纯化的菌种进行培养,持续观察发现8株菌株在PDA培养基上显示出不同的菌落形态特征。超景深三维显微系统观察菌丝和孢子的微观形态,并显微拍照显示如下:
菌株1(见图1)菌落生长稍局限,菌落初为白色,反面略带黄色,产生大量黑色孢子。菌丝呈黑褐色,分生孢子梗顶端膨大顶囊大球形,小梗双层,分生孢子为球形,呈黑或黑褐色。
菌株2(见图2)菌落生长局限,蓝绿色,边缘白色,反面乳白色,有明显的渗出液。气生菌丝密毡状。分生孢子球形,分生孢子梗末端形成扫帚状分枝轮。
菌株3(见图3)菌落墨绿色,中间肉粉色,边缘白色。分生孢子梗形成帚状枝,分生孢子球形。
菌株4(见图4)菌落生长迅速,呈白色或浅粉色的棉絮状,菌落反面黄色。大型分生孢子无色,纺锤形,1-5个隔膜。
菌株5(见图5)菌落墨绿色致密绒状,边缘白色,菌落反面初为乳黄色,后为暗绿色。分生孢子梗形成非对称形帚状枝,分生孢子球形。
菌株6(见图6)菌落生长缓慢,厚绒状,表面扁平,墨绿色,边缘白色,反面同色。镜下可见菌丝细枝状,为有隔菌丝。
菌株7(见图7)菌落质地丝绒状最初白色,后期淡褐色,菌落反面略带黄色。无渗出液;有霉味。生长速度相对较快,在28℃条件下,4天长满9cm的平板。
菌株8(见图8)菌落质地疏松,最初带黄色,然后变为黄绿色,老后颜色变暗,平坦,反面无色。镜下可见较粗的分生孢子头,顶端膨大形成顶囊,顶囊上有小梗,小梗上有许多小分生孢子,分生孢子球形。
编号1-8号菌株在PDA培养基上生长的菌落正反面形态特征
(2)分子生物学鉴定结果
本次在档案黑色斑点处采集培养的霉菌分离出8种5个属(见表),均为能对纸质档案载体产生危害的常见菌种。纸质文物上污渍相关的真菌属主要为曲霉(29%)和青霉(13%),本次污损档案所采菌样也以青霉、曲霉居多。有的产色素污损档案,有的产酸增加纸张的酸度,有的分泌纤维素酶,造成纸张强度下降,有的代谢产物具有挥发性,污染库房空气质量。因此研究着生于纸张档案上的霉菌种类及其特性,对于纸质档案的保护、霉斑的去除,以及库房空气污染的治理都是非常必要。本次培养出的8株霉菌,其中:
菌株1、菌株8:属于曲霉属,曲霉属分布广泛,是引起多种物质霉腐的主要微生物之一,在档案馆中,皮革类、纸质、装具以及墙壁都曾有曲霉属的检出。黄曲霉( Aspergillus flavus)可分泌I型和II型α-D-木糖苷酶、果胶酶、淀粉酶、蛋白酶和脂酶等其他酶类,在侵染寄主的过程中降解寄主组织,曲霉孢子呈绿、黄、橙、褐、黑等颜色。黑曲霉在生成孢子的同时分泌黑色素污损档案,产生葡萄糖酸、柠檬酸、木质纤维素降解酶,增加纸张酸度,降低纸张强度,纸张出现发黄、变脆、颜色加深。
菌株2、菌株3、菌株5:属于青霉属,青霉属营养菌丝体无色、淡色或具鲜明颜色,分生孢子呈绿色,蓝色或黄色,即通常看到的各种青霉菌落特有的颜色。青霉和曲霉所呈现出的不同颜色,都是由孢子的颜色造成的。它们的菌丝内不含色素,是无色的。曲霉属的纤维素酶酶活和木聚糖酶酶活皆高于其他菌属。青霉属的酶活次之。真菌具有较高的代谢酶活性,其中曲霉属和青霉属酶活总体水平较高,故而成为降解馆藏纸质档案的主要优势微生物。
菌株4:属于镰孢属,气生菌丝白色绒毛状,在PDA培养基上底部呈淡黄色;
菌株6:属于枝孢菌属,菌丝带有颜色,菌落整体呈现深绿色,枝孢霉的孢子分布广泛,库房空气微生物检测中经常会发现枝孢霉的存在,当汛期库房湿度大的时候,孢子沉降到载体表面生长繁殖。空气中传播的枝孢霉孢子是极重要的过敏原,枝孢霉不会产生任何主要的毒枝菌素,但是可产生结构多样性的次生代谢产物,如生物碱,内酯,醌类和类固醇,由于代谢产物具有挥发性,会引起库房空气中易挥发性有机物(VOC)数值增大,从而影响库房空气质量,并产生异味。
菌株7:属于毛壳属,毛壳菌属广泛分布于自然界中各种含纤维素的基物上,能够产生大量的纤维素酶,降解纤维素,水解成葡萄糖,是造成纸质档案物理性能下降的主要病害真菌之一。
菌株编号 | 序列比对菌株种属名 |
1 | Aspergillus曲霉属,推测为Aspergillus niger(黑曲霉) |
2 | Penicillium(青霉属) |
3 | Penicillium(青霉属) |
4 | Fusarium(镰孢属),推测为Fusarium equiseti(木贼镰孢) |
5 | Penicillium(青霉属) |
6 | Cladosporium(枝孢菌属) |
7 | Chaetomium(毛壳属),推测为Chaetomium globosum(球毛壳) |
8 | Aspergillus(曲霉属) |
18S和ITS分子生物学鉴定结果
密闭高湿环境下纸张生霉形成霉斑情况观察
将三种纸张(净皮生宣、新闻纸、胶版纸)放置于金属托盘中,放入密闭的培养箱。15天后观察发现,胶版纸大面积生霉且纸张局部变黄,新闻纸和净皮生宣也出现霉点,但从面积和颜色来看,远不及胶版纸严重。胶版纸纸张表面肉眼可见大面积菌落,且出现纸张变色情况(见图9)。裁取部分生霉胶版纸在显微镜下观察(见图10)。实验纸张取出时检测环境温度27℃,湿度36.9%,培养箱内温度26.4℃,湿度85.4%,实验可见,在高湿避光密闭条件下,纸张在短短两周内就出现肉眼可见的大面积生霉,并且不同材质的纸张在生霉速度上差异很大。
酒精擦除效果观察。笔者用棉拭子蘸取75%酒精擦拭本文上述实验中的生霉胶版纸,并使用超景深三维显微系统观察擦拭效果(见图11)。可见擦拭去除了纸张表面的菌丝及孢子,仍有部分菌丝残留在纸张纤维内部。把擦拭过的纸样以及用过的棉拭子经过洗脱接种到培养基上,仍然可以生成菌落。

密闭高湿环境下胶板纸张生霉形成霉斑及酒精消毒后情况
某市级档案馆一间纸质档案库房连续三年的温湿度趋势
华中地区某市级档案馆的库房按照档案馆建筑设计规范建设,采用有助于库房温湿度环境稳定的新型建筑材料,配备有除湿机。通过对近三年库房温湿度监控数据进行分析,发现2020年6-9月、2021年7-10月、2022年6-9月,库房月平均温度大于24℃,月平均湿度大于60%,每年会有长达4个月时间库房温湿度平均值高于《档案馆建筑设计规范》JGJ25—2010中纸质档案库的温度14℃~24℃,湿度45%~60%的规定范围。
纸张是由长短不同的植物纤维叠搭交织而形成的具有各向异性的多毛细孔隙网状结构,具有较强的亲水性和吸附性。环境湿度对纸张含水量的影响实验结果表明:在同一环境湿度下,不同纸张的含水量不同,但纸张含水量随着环境湿度的增大而增大,在相对湿度达到60%~70%时,纸张含水量变化速率最大。由于纸张抄造工艺过程不同,环境湿度对不同种类纸张含水量影响不一致。监测某档案馆三年的湿度趋势显示(见下图),汛期6-10月库房湿度正好处于纸张含水量随环境湿度变化速率最大的区间。

某档案馆2020-2022年年的温湿度监测变化趋势
讨论与建议
档案馆为防止新入馆档案带入潜在的生物污染,对进馆档案采用低温冷冻的处理方式,并在修复生霉档案时采用酒精擦拭的方式除霉是一种常见的做法。实验观察这两种操作对霉菌的杀灭和去除效果,发现这两种处理方式对霉菌的杀灭并不彻底,霉菌在适当的条件下仍可以培养成活。
(1)每年6-10月的汛期,档案存储环境受外界影响,容易出现湿度长时间超过标准范围的情况,这种条件下霉菌孢子易于萌发,生长蔓延速度加快,档案工作人员要加强对档案生霉的检查力度和频次,曾经生霉的档案要着重检查,以防去除不彻底,霉菌再度萌发危害档案。
(2)从纸张生霉实验可以看出,不同纸质档案载体生霉以及蔓延速度区别很大,检查时对于易生霉的纸质档案要着重检查。对于被菌丝发达,生长蔓延迅速,产酸和形成色素的霉菌污染的档案要优先介入处理,以防造成进一步损毁。
(3)低温冷冻可以杀灭档案害虫,抑制霉菌的生长蔓延速度和代谢活性。在本实验中,经低温冷冻的霉斑仍具有活性也可看出这种方法无法彻底杀灭纸张上的霉菌。进馆档案若发现有生霉迹象,还应采取其他更为有效的灭菌措施。
(4)霉斑由于种类、档案载体材质、产生的时间等因素,去除的难度存在较大差异。通常来说,生长初期的菌落,菌丝未深入纸张纤维内部,产生的色素也比较浅,较为容易清除。一旦菌丝、色素深入纸张纤维,产生顽固霉斑,如需去除,均会对纸质载体造成一定的影响。因此无论是从清理操作难易的角度还是对档案载体损害的角度来说,都应早发现早修复。
(5)纸质档案表面被真菌污染呈现的颜色,通常是真菌孢子的颜色,而纸张载体变色则可能与真菌利用载体的营养成分而产生的水溶性色素相关。微生物色素是一种次生代谢产物,与菌体的生长繁殖没有明确关系,一般在其生长到达一定阶段后产生。因此及时发现微生物污染,并采取灭活手段,才能阻止并减小霉菌对档案载体的污损。
(6)酒精擦拭过的生霉档案,可以有效减少档案载体表面的菌丝和孢子,但残留的菌丝仍对档案安全造成威胁。真菌的菌丝一般由孢子萌发产生的芽管发育而成,除具有繁殖作用外,主要的作用是生长蔓延、吸收营养,纸张上的霉菌菌丝吸收营养的过程伴随分泌各种有机酸和分解纤维素的酶类的产生,也是纸张被霉菌侵蚀的过程。菌丝的再生能力很强,菌丝片段能够单独传播,发展成新个体。
(7)微生物分子生态学研究表明,自然界中绝大多数微生物物种细胞尚不能被现有的微生物培养方法和技术进行复苏、分离和培养。基于培养的方法在很大程度上筛选限制了潜在的微生物类群,这类方法仅能获得当前微生物多样性的有限部分。研究和认识档案载体上的微生物,特别是研究微生物对档案的影响,离不开微生物分离培养技术,而能否培养成活与采样方法、保存条件、培养条件等密切相关。虽然本实验培养出了8株分属于5个属的霉菌,但采用宏基因测序的方式则得到了更多的霉菌和细菌种类。
“原文刊发在《档案学研究》2024.2期”

公司传真
021-6608 2117
公司电话
021-6608 2110
上班时间
周一~周五